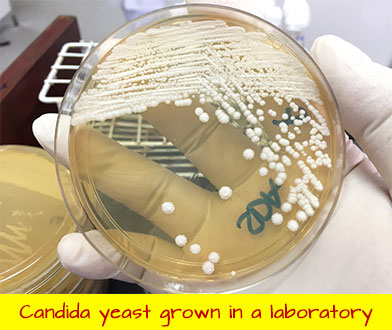

Candida Yeast Score:
Likelihood of Yeast Infection: MODERATE
(Probability: 54% or Higher)
Hey there, thanks for taking our quiz :)
Based on your score of there’s a MODERATE probability you’re suffering from several Candida yeast infection symptoms such as gas, bloating, sugar cravings & indigestion.
Please read the following for an in-depth guide on how to get rid of these symptoms.
In Case You're Not Familiar With Us or What We Do...
We launched CanXida in 2013 to give people like you all the tools & free educational materials needed to finally heal your gut from Candida, Leaky Gut, IBS, SIBO & (almost) any other gut issue.
In addition to making quizzes and writing articles...
We've created a natural yeast-eradicating supplement called CanXida Remove (also known as RMV) which you can learn more about later.
We also run the world's largest Candida and gut disorder related YouTube channel (called CanXida) we currently have 2,993 free educational videos (along with several ebooks) that teach you step-by step how to heal your gut from Candida, IBS & more.
Most were made by our cofounder before he closed his naturopathic (natural medicine) clinic in 2019 after +30 years of clinical practice.
There's no ads and no membership to buy. Everything is 100% free.
Why do we give so much away for free? Because we like to see people recover. It’s fantastic and the best part of our job. At the time of writing this, we have 162,089 YouTube subscribers and over 16 million video views.
We launched CanXida in 2013 to give people like you all the tools & free educational materials needed to finally heal your gut from Candida, Leaky Gut, IBS, SIBO & (almost) any other gut issue.
In addition to making quizzes and writing articles...
We've created a natural yeast-eradicating supplement called CanXida Remove (RMV) which you can learn more about later.
We also run the world's largest Candida and gut health related YouTube channel (called CanXida) where we currently have 2,993 free educational videos (along with several ebooks) that teach you step-by step how to heal your gut from Candida, IBS & more.
Why do we give so much away for free?
Because we like to see people recover. It’s fantastic and the best part of our job. At the time of writing this, we have 162,089 YouTube subscribers and over 16 million video views.

Since you took our quiz, we'd also like to give you a free PDF copy of our most in-depth book — Candida Crusher (718 pages), along with every other ebook we've written.
You'll learn how you can get them towards the middle of this page.
This is the type of work we do.
That's why we can say with 100% certainty – if you give us your FULL ATTENTION for the next few minutes...
You're going to get a very clear picture of exactly how to permanently eliminate all traces of Candida from your body and get your digestion working properly again.
And as you'll see when we get to the case studies further in this page, this method already has a reputation for finally getting patients results after years of diets & drug treatments got them nowhere...
A lot of patients come to us with the idea that Candida is incredibly difficult to get rid of.
Often times they've been to a dozen or more practitioners & natural health doctors before finding our videos.
Since you took our quiz, we'd like to give you a free PDF copy of our most popular book — Candida Crusher (718 pages), along with every other ebook we've written.
You'll learn how you can get them towards the middle of this page.
This is the type of work we do.
That's why we can say with 100% certainty – if you give us your FULL ATTENTION for the next few minutes...
You're going to get a very clear picture of exactly how to permanently eliminate all traces of Candida from your body and get your digestion working properly again.
And as you'll see when we get to the case studies further in this page, this method already has a reputation for finally getting patients results after years of diets & drug treatments got them nowhere...
A lot of patients come to us with the idea that Candida is incredibly difficult to get rid of.
Often times they've been to a dozen or more practitioners & natural health doctors before finding our videos.
Because the Truth Is... Candida Is Actually EASY to Eradicate... There's Just 3 Things You Need To Do...
Here's what you need to know about Candida before we explain our method...
1. Candida yeast infections are caused by a naturally occurring yeast-like fungus found in the GI tract of 90% of the population & because it is a fungus – it is HIGHLY susceptible to antifungal treatments.
2. Candida is an opportunistic pathogen –meaning it's NOT a problem when kept in check by friendly bacteria but will become a problem when those bacteria are no longer present.
This is why yeast infections are often triggered by antibiotics and why it's 100% IMPOSSIBLE to permanently get rid of Candida UNLESS your treatment plan includes a stage where we recolonize your gut with friendly bacteria.
Not doing this CRUCIAL step is the #1 reason many people get recurring infections and end up suffering for years.
As you know, long term digestive problems are often the first sign.
From there Candida spreads or migrates to the vagina in women or other parts of the body.
When grown in the lab, Candida appears as a large, round, white or cream colony. That's why Candida Albicans infections (thrush) often feature white mouth lesions.
But...
Even Though There's Lots of Scientific Literature On Candida Today – the Average Doctor Still Doesn't Know How to Respond
Candida is almost always misdiagnosed.
Stool testing is not performed. Neither is a urinary culture nor a smear test for thrush.
Even those in the medical establishment who pay attention to Candida often treat it as a local problem or simply see it as a "nuisance" & a "woman's problem" even though many men have it too.
It's also often incorrectly labeled as IBS or Irritable Bowel Syndrome.
IBS is what we call a garbage-can diagnosis. It's where doctors lump you into when they have NO IDEA what the heck is wrong. The truth is, IBS will clear up to a remarkable degree once we get rid of any bad bacteria & parasites in your gut and reduce Candida to low levels.
You should also note that...
Candida is almost always misdiagnosed.
Stool testing is not performed. Neither is a urinary culture nor a smear test for thrush.
Even those in the medical establishment who pay attention to Candida often treat it as a local problem or simply see it as a "nuisance" & a "woman's problem" even though many men have it too.
It's also often incorrectly labeled as IBS or Irritable Bowel Syndrome.
IBS is what we call a garbage-can diagnosis. It's where doctors lump you into when they have NO IDEA what the heck is wrong.
The truth is, IBS will clear up to a remarkable degree once we get rid of any bad bacteria & parasites in your gut and reduce Candida to low levels.
You should also note that...
Conventional Doctors Give Antibiotics KNOWING FULL WELL the Side Effects Can Include the NIGHTMARISH Digestive Problems & EMBARRASSING Symptoms You're Dealing With Right Now
They know antibiotics can trigger yeast infections & gut problems.
In fact, they're trained to see what you're going through as a "MINOR SIDE-EFFECT" (even though you're well aware it's NOT minor at all).
Even crazier, many conventional doctors confuse Candida with a bacterial infection & give additional antibiotics – TOTALLY OBLIVIOUS those same antibiotics are what caused the problem in the first place!
Not a good idea...
Antibiotics have a very powerful disturbing effect on the good bacteria levels of the large intestine.
They also create an environment where nasty bugs like bacteroides, E. coli, clostridium difficile and yeasts such as Candida can
flourish without opposition.
You Would Think Natural Doctors Would Be Far More Effective But...
Unfortunately when it comes to chronic Candida, natural doctors aren't much different from conventional doctors.
Even if it is diagnosed, it's not treated adequately or given the attention it deserves.
They also don't do the proper tests for it like a CDSA x3 (stands for Comprehensive Digestive Stool Analysis w/ Parasitology, 3 samples) which in our experience is the #1 best test you can do to find out what's REALLY wrong with your gut.
We're always amazed how often people find our YouTube channel after being to a dozen or more natural health doctors or "gut specialists" NEVER having had a CDSA x3 test performed or even heard of one!
Click the image above to watch video
Furthermore, they too often treat Candida as SIBO (Small Intestinal Bacterial Overgrowth) or simply label it as food allergies or gluten intolerance (this is a BIG one).
Or they just say it's Leaky Gut, IBS, etc.
Here Are the Two Main Drugs Doctors Prescribe For Candida – & Why You Should Stay Away From Both
1. The "Nystatin" Drugs
These are drug-based antifungals that start with the letters "nys" or "nystat." There's 3 main ones which you've likely heard of before. These were promoted back in the 1980's as being one of the best & "safest" pharmaceutical antifungals because they're not absorbed by the GI tract & don't harm beneficial bacteria.
They work by interfering with the integrity of yeast cell membranes (causing them to break down).
And that sounds great, however...
These drugs cause very bad Herxheimer reactions (aka Candida die-off) which can range from mild to severe. If you ask around, you'll find the majority of patients who tried these drugs got very ill indeed...
This happens because as Candida dies, it releases toxic cell fragments. And these then get released into your bloodstream and can cause havoc on the immune system...
Triggering symptoms like brain fog, bloating, nausea, skin rashes, fatigue, headaches...
That's why you want to kill yeast SLOWLY over time – you want to MINIMIZE how many toxic Candida cell fragments are in your bloodstream at once. Otherwise you're going to be miserable during your treatment.
A Lot of People Have This Weird Idea That You Can Kill All the Candida In Your Body Within 24 Hours If You Just Use the "Right Trick"
Not only is that not possible, but the die-off reaction from something like that is probably going to be so strong...
YOU'LL END UP IN A COMA!
Especially if your Candida is severe. So think about that next time you see one of those blog posts that promise you instant cures.
Taking nystatin is a surefire way to take your already bad symptoms & make them FAR worse...
We don't recommend it.
2. The "Azole" Drugs
These are drugs that end with the letters "azole" or "izone" such as metronidazole. Chances are you've already tried one of these drugs in the past. The most potent ones are often used intravenously (via injection).
These drugs work by inhibiting an enzyme necessary for fungal membrane function. Without this enzyme Candida can no longer grow and starts to die.
Again, sounds great... until you see the side effects...
Sudden loss of kidney function, difficulty breathing, abnormal liver function, rash, diarrhea, lung spasms, intestinal bleeding, and many others.
We tell our patients to STAY AWAY.
What's Worse Is These Treatments Don't Even Work Long Term
Because not only will Candida almost always develop a RESISTANCE to these drugs, requiring you to take higher doses for longer periods of time...
These treatments do NOTHING to prevent Candida from coming back several months to a year later.
Especially because these untrained practitioners NEVER take the necessary steps to strengthen and recolonize your gut with the friendly bacteria that keep Candida in check!
This is why you often see patients struggling with this illness for YEARS.
Our Approach Is VERY Different – It Not Only FULLY Rids Your Body of Candida & Keeps It From Coming Back – It Also Gets Rid of Bad Bacteria, Parasites, Food-Allergies, Skin Problems, Digestion Issues & MORE
As you noticed if you checked the YouTube channel, we've been at this for a while.
The information we share is based on over 30 years of research working solely with candida yeast infections (as well as other gut disorders "conventional" medicine couldn't fix).
That's why we can say WITHOUT A SHADOW OF A DOUBT the Candida method you're about to learn works.
It works no matter how sick you are, how long you've been struggling with candida, how many previous treatments you've tried or how many "specialists" you've been to.
Our 3 part protocol is very simple to understand, easy to follow and has NO-SIDE EFFECTS.
Here's how it works:

We promise you, once you do these 3 things, Candida will no longer be able to survive in your body.
The first step we're going to talk to you about is diet.
There are 3 phases to our anti-candida diet. These are also the 3 stages of recovery.
We'll only go over diet briefly on this page. You'll get all the food lists and details on what to eat & avoid when you watch our grab our free eBooks. We've got over 200 pages on diet alone in Chapter 7 of our 718-page Candida Crusher ebook too. You'll learn how to get it for free towards the middle of this page.
So let's get started...
The CanXida Protocol: Part 1
The 3 Phase Anti-Candida Diet
Phase 1: The MEVY Diet
MEVY is an acronym for meat, eggs, vegetables and yogurt.
The MEVY diet is basically an anti-candida diet that's high in protein and very low in sugar. It takes away the food source of yeast. Candida loves sugar. It does not like to thrive on lean meat, blueberries, avocados, green apples, yogurt, fresh vegetables and eggs.
It’s a tasty and healthy diet. You’re not going to starve or feel deprived.
Meats generally are not favored at all by Candida.
You're not going to have a problem with fresh fish, lean beef, or free range eggs.
Just be careful not to overload your diet on red meat because that can cause constipation and clogged up bowels.
If you’re a vegan there’s plenty of other options you’ve got.
We also have a list of special high cleansing foods you can read about in Section 4 of Chapter 7 of Candida Crusher. These include oregano, coconut, garlic, onion, cloves...
These foods discourage bad bacteria like Citrobacter freundii & get rid of microscopic parasites like Blastocystis and other nasty bugs we typically find when we test Candida patients.
We don't need to go into all the different kinds of vegetables and fruits you can eat & which aren't allowed.
You can learn all about that in our PDF's and videos.
The MEVY diet works because it starves the Candida. It's a well tested diet that's been around for about 45 years.
If you're like most patients you'll notice an improvement in your digestion within two to three weeks.
Exactly how long you'll need to stay on the MEVY phase depends on how bad your symptoms are and how long you've been sick.
We recommend people stay on the MEVY diet for a period of at least one month. After that we transition you to what's called the Low Allergy phase.
Phase 2: The Low Allergy Diet
Now that Candida has been weakened, we can start restoring your gut's immune system.
Most people with a chronic yeast infection will have leaky gut syndrome and a background of antibiotics use. They'll have poor levels of good bacteria and all sorts of gastrointestinal distress.
That's why it's best to come off what we consider the key allergy foods.
These Foods Include:
- citrus (especially oranges)
- pineapple
- banana
- shellfish
- peanut/peanut butter
- wheat/gluten
- chocolate
- cow's milk
Our team did a lot of testing on over 350 young children & found nearly 70% had a problem with cow's milk. Bananas came back around 14%. Pineapples and shellfish came back nearly 20%.
Bread and gluten allergy is not as common as you think.
Chocolate however is. Even dark chocolate, 70% cocoa or whatever it is, it's GOT TO GO for a while.
Chocolate aggravates Candida symptoms.
Even if it's raw cacao you need to take it out of your diet for at least 3 to 4 weeks. You can go back to eating it later.
A Note on Wheat:
Too many people point the finger at wheat and gluten when in fact, these people have bacterial and yeast problems that need clearing up before they start taking gluten out of their diet.
We're not here to tell you to eliminate all wheat or gluten out of your diet.
In Fact, We've Helped Hundreds of People Get BACK into Gluten After They Were Told By Doctors They Could NEVER Eat Wheat Again
Because once your gut bacteria levels are restored – gluten is no longer a problem.
Just because every blog site out there says you should eat gluten-free doesn't make it true. "Gluten free" is like a religion today.
Remember, only 1 or 2% of the population has Celiac Disease.
Are you celiac? Probably not.
Are you gluten intolerant? Probably not.
Do you have an imbalanced gut? Probably yes.
What we're doing with the Low Allergy Diet is taking out the foods that could potentially trigger an immune response.
This is very smart because you've likely got food allergies and intolerances right now that are creating immune dysfunction. All patients with Candida do.
We Also Know For A Fact That Nearly ALL Patients With Candida Have LEAKY GUT – Whether They Realize It Or Not
By taking all these foods out, it stops the immune system from reacting.
Because remember, the purpose of this treatment plan is to NOT justy to remove Candida from your gut...
It's to REBUILD and STRENGTHEN your digestive system so you no longer have to worry that the next bite of the "wrong food" will trigger a toilet nightmare for the next 24 hours.
That's why phase 3 is called the "re-introduction diet"...
Phase 3: The Re-Introduction Diet:
Now that you're feeling a lot better and most of your big symptoms have disappeared, we start reintroducing the foods that we eliminated in phase 1.
You'll get the exact details later but what you'll basically do is get a piece of paper and write down all the foods you really love but feel you can't eat because they give you stomach problems.
I'm talking about ice cream, beer, wine, pizza, chocolate chip cookies, pastries, whatever you like.
Then what you'll do is slowly start to reintroduce these foods & see what effect they have on you.
Yes, even ice cream and burgers.
We don't like being the "food police."
And it may sound shocking but once you RESTORE your gut, you'll be VERY SURPRISED to find that most (if not all) the foods currently on your "to avoid" list no longer give you trouble.
Of course this doesn't mean you can go on a 100% junk food diet and expect to stay healthy, but you can be sure an occasional milkshake or pizza with friends isn't going to bother you anymore.
Gone will be all your worries about what's "safe to eat."
Gone will be the restrictive diets and thoughts that "my stomach can't handle this."
Because Once You Go Through Our System You'll Be Able to Eat Whatever You Like Without Fear of Bloating, Gas, Diarrhea, "Fishy Smell" Or Any Other Nasty Or Embarrassing Symptoms!
You don't have to be gluten, dairy, sugar, alcohol or whatever else free for the rest of your life.
We can tell you now after helping thousands of folks overcome Candida – PEOPLE GET SICK AND TIRED of these restrictive diets.
They hate them.
Every label has got to be scrutinized rigorously.
Every time you go out with friends 90% or more of the menu is off limits and you're stuck with the blandest salad.
What a pain in the butt!
Over the Years We Noticed the Sickest Patient Often Has the Best Diet
THE BEST!
And they're still sick.
They've been gluten, dairy, soy-free and raw vegan for 10 years – and they look terrible!
All they have is anxiety about food.
They say"Oh, but I've been eating all this and I'm eating all that." If everything is so good then why are you so sick all the time?
Don't be an extremist about food. Please don't do it.
Here's A Short Summary of Our 3-Phase Anti-Candida Diet
Phase 1: The MEVY Diet:
We put you on a high protein diet with plenty of fiber and vegetable starches for your good bacteria to feed on. This starves the Candida and bad bacteria while at the same time encouraging the growth of friendly bacteria.
Phase 1 is also known as the Candida removal phase.
Phase 2: The Low-Allergy Diet:
Next we improve your immune function by removing all the potentially allergenic foods that could trigger an immune response. This is very clever because if done right, once your gut health is restored you're going to notice that a lot of your food allergies & sensitivities disappear.
So you can go back to eating like a normal person again, go out to restaurants with friends and enjoy family dinners again like you used. Phase 2 is also known as the gut restoration phase.
Phase 3: The Re-Introduction Diet:
This is where we start slowly reintroducing the foods we took out in phase 1. The purpose of this stage is to build a solid foundation for your future digestive health. Phase 3 is also known as the gut rebuilding phase.
Don't worry if you don't fully understand all this yet, everything will become clear once you finish reading this page and get our Candida Crusher eBook.
The process is very strategic.
Basically ... We're Transforming Your Gut From A Place Where Yeast, Bad Bacteria & Parasites Can THRIVE Unchallenged – Into A Place That's HOSTILE to Them & Instead Encouraging to Friendly Bacteria
Here's a more scientific explanation for you.
See that diagram below? That's how the lining of your gut looks like right now.
The way digestion works is food matter passes through your gut & rubs against millions of tiny microscopic "bristles" that line the villi of your gut wall.
These bristles are called microvilli.
In healthy people, these microvilli are coated with a thick layer of friendly bacteria which helps break down food and fights off any yeast, parasites, & bad bacteria that passes by.
In other terms, these friendly bacteria that live on your microvilli are your gut's IMMUNE SYSTEM.
However... if you've got Candida...
Instead of having this coating of friendly bacteria, you've got a thick layer of yeast and likely also a few toxin producing bad bacteria such as bacteroides, clostridium difficile, or pseudomonas.
And that's what's making you sick right now.
All that being said...
Please Understand That While Diet Is VERY IMPORTANT It's Only One Of Three Things You Must Do For A Full, Permanent Recovery
A lot of patients ask if it's possible to recover from Candida with just diet alone.
And the answer is yes, but it's hard, REAL HARD.
We've only seen it happen a few times in patients with mild Candida. If you've got moderate to severe symptoms, forget about it.
Let us phrase that another way.
If You've Got Severe Candida – You Will NOT Get Rid Of It With Diet Alone
You will not get rid of Candida with diet alone or with supplements alone.
If you're looking for a quick fix you may as well close this page right now and look elsewhere.
Candida is VERY EASY to get rid of IF you're willing to do ALL 3 of the things we outline on this page AND stick with them for a period of at least one to three months.
With that being said, let's move on to lifestyle.
The CanXida Protocol Part 2:
The Anti-Candida Lifestyle
Lifestyle is a subject almost nobody talks about.
Most Candida websites talk very little about lifestyle if at all.
But as you're going to see in a moment, lifestyle is at least 1/3rd of the recovery equation.
You may not be aware of this, but lifestyle affects your immune system. It affects your endocrine system, your hormonal system, and your nervous system.
And If This Is Something You Don't Want To Hear I'm Sorry But It's Very Important That You Hear It From Someone Because...
You're going to have a VERY HARD TIME beating Candida if you regularly go to bed at 3 am right after spending an hour looking at your iPad.
You're going to have a very hard time beating Candida if you're living in a situation with bad relationships or have a lot of stress constantly hanging over your head.
Maybe you have a stressful job or kids to take care of, we get it.
You need what's called "leisure time" or "relaxation time" (something most people just don't get enough of today).
Even if it's just 30 minutes a day.
This Isn't Some Whoo-Whoo Mental Health Fluff – Leisure Time Activates What's Called the Parasympathetic Nervous System – This is What Heals & Rebuilds Your Body & Helps It Cleanse Itself
Think about it.
What's the #1 thing you do if you're ill with a fever or have some sort of physical injury?
You get proper rest. You try to relax and engage in low stress activities that you enjoy.
Of course we're not telling you that you need to take off work for months and stay home. But you do need to realize that the more stress you've got in your life, the longer your recovery is going to take.
You also need to start paying more attention to your sleeping habits because the parasympathetic nervous system is most active when you sleep.
Over 40% of people in the U.S. have some sleeping issues. It's a big problem.
If you've been suffering with gut problems for a while I'm sure you've noticed your how much stress affects your bowel movements & how you always get symptoms at the worst possible times.
This is because the autonomic nervous system which controls digestion and the movement of food through your gut easily gets screwed up with stress. Stress also causes inflammation of the gastrointestinal system & can make your digestion shut down.
Trust us, that's NOT the state you want to be in if you're looking to heal.
You're Making a BIG MISTAKE If You Think You Can Beat Candida By Eating Some Vegetables & Swallowing a Few Pills
You're only fooling yourself.
Lifestyle is a BIG part of recovery.
Seriously, if you ignore lifestyle you're likely wasting your time reading this because you're not going to fix Candida via supplements and diet alone.
In some cases, you can. But in chronic cases, you won't.
We've seen thousands of patients who had been sick for YEARS recover in one to two months using the protocol on this page. They understood the importance of lifestyle. We hope you do too.
You'll learn more about this in our ebook plus YouTube videos.
The CanXida Protocol Part 3:
Anti-Candida Supplements
As we're sure you're aware, there's a lot of supplements out there that claim to work on Candida. Some patients think you need to take loads of stuff (like 20 pills a day!).
But the truth is, you only need 1 or 2 when it comes to recovery.
Chances are you're already tried taking supplements for gut health. Most didn't work so well did they?
That's because most Candida supplements these days are TRASH.
They’re put together by marketers. They aren’t put together by someone with experience treating actual patients. They’re released by companies that have 100 other products and pay lip service to making a Candida cleanse formula or a probiotic.
Many supplements these days are filled with fake ingredients.
Click the image above to watch video
This isn’t our opinion. It’s a fact.
Back in 2015, the New York Attorney General Office conducted 390 tests on a wide range of supplements. They gathered bottles from the shelves of 4 major retail stores.
These were GNC, Target, Walmart and Walgreens. They then sent the bottles over to a lab and DNA tested every tablet to see if the ingredients matched the label. And guess what they found.
Only 21% of the products actually had the herbs advertised on the bottle.
79% didn’t contain ANY of the herbs and were just full of junk like rice powder and wheat!
Here’s a screenshot of an article from CBS News on Feb 3rd, 2015, reporting on it:

And it gets worse...
One survey done by the FDA found 68% of the supplements tested didn’t even have the MAIN INGREDIENT advertised on the bottle. For example, one St. John’s Wort supplement contained nothing but laxatives.
This is why it’s best to avoid generic brand supplements from places like Amazon or iHerb.
The way you find good supplements is by asking “Where did this product come from? Where did the company get the raw materials? What kind of research has gone into this product?”
“What country did the ingredients come from?”
Was the product formulated by a person who’s an expert on it? Has it been tested and proven to work for your specific problem? Do they provide extensive education about dosage or the best way to use this product?
Our CanXida formulas have over 30 years of research behind them.
We know they work because we've done stool testing.
Over 100 CDSA x3 (Comprehensive Digestive Stool Analysis) lab tests were conducted before, during & after a patient took CanXida. You can see these tests in some of the YouTube videos on this page.
Click the image above to watch video
Our first formula was called CanXida Remove (RMV) — a natural cleansing tablet.
It was very difficult to manufacture (nothing good is easy to achieve).
The first batch (back in 2013) sold out very, very quickly & we got incredibly good feedback on it. Since then it's been reformulated, sold out several more times & used by thousands of Candida sufferers around the world.
And the results have been nothing short of outstanding...
We've since made 3 other Canxida formulas, including an extremely powerful probiotic + enzyme formula called CanXida Restore.
But we're getting ahead of ourselves...
Introducing CanXida Remove – the World's First Clinically Tested Natural Antifungal Specifically Designed to Work Even In Very SEVERE Cases Where the Patient Has Been Sick for YEARS & Everything They Tried Failed or Symptoms Came Back
CanXida Remove (RMV) is a clinically-tested 12-ingredient antifungal, antibacterial & antiparasitic tablet designed to remove the ROOT CAUSE of gut disorders — an overgrowth of yeast, bad bacteria & parasites (so your friendly bacteria takes back control).
Remove the only formula that targets the BIG PICTURE of gut disturbances & is in my opinion the most premium gut cleaning supplement ever created.
Unlike most other "heavy-duty" cleansing formulas, RMV doesn't kill beneficial bacteria.

Symptoms Addressed by CanXida Remove (RMV):
- Severe gas & bloating
- Unexplained constipation & diarrhea
- Stomach or abdominal pain caused by indigestion
- Vaginal thrush (aka vaginal discharge & “fishy smell”) and jock itch
- Recurring toenail fungus (and fungus infections in general)
- Oral yeast infection symptoms such as white tongue
- Sugar cravings (these are often caused by yeast)
- Severe lack of energy, fatigue and tiredness (often caused by adrenal fatigue)
- Inability to lose weight
- Persistent itchy skin rashes caused by fungal overgrowth
- Symptoms attributed to IBS (irritable bowel syndrome), SIBO (Small Intestine Bacterial Overgrowth), and Leaky Gut Syndrome
Note: Also targets secondary infections caused by long term gut issues such as dysbiosis (poor beneficial bacterial levels) and microscopic parasite infections such as Blastocystis & Hafnia (because once your gut has candida & low levels of “friendly” bacteria it’s not hard for other “bad guys” to get in).
Also effective against bad bacteria that have become resistant to antibiotic medications (common in patients who've been on many rounds of antibiotics & no longer feel any results from them, even short term).
A Quick Note On Parasites You MUST Read
A lot of patients get freaked out when we mention gut parasites.
They immediately get scary visions of monsters or slimy worms with hooks. Something that gets inside you, rips your intestines apart and comes out of your bum and wiggles around in the toilet.
Forget all that stuff.
Most parasites are so small you can't even see the darn things without a microscope.
And even then you sometimes need DNA technology (such as a PCR test, which very few doctors know how to perform) to determine if there's a parasite in the stool or not.
So... Sorry To Tell You This But... The Chances You've Got A Parasite Infection Are Quite HIGH These Days
Especially if you've got Candida.
One of the common signs is a bowel function disorder such as unexplained constipation, gas, diarrhea or IBS.
Another one is persistent itchy skin around the thighs or upper arms or neck or itchy bum, as well as fatigue & never feeling full or satisfied after a meal.
Because the problem with Candida is once you start getting gut imbalances
(low beneficial bacteria, high levels of yeast & bad bacteria)
it's not hard for other "bad guys" to get in.
And as unpleasant as it may be to hear, it's very common.
Bugs with weird names like Dientamoeba fragilis, Blastocystis hominis, Hafnia and more.
Over 50% of stool samples from Candida patients these days have at least one of these, with Blastocystis being the most common.
The Good News Is That Parasite Infections Respond Remarkably Well To Natural Treatment
More so than even pharmaceutical drugs because natural medicines don't kill beneficial bacteria.
That's why CanXida Remove has anti-parasite ingredients like grapefruit seed extract, undecenoic acid, berberine and black walnut hull.
Another benefit of natural medicine is resistance doesn't occur with natural ingredients. That only happens with drugs.
This has been confirmed many times with studies done on things like grapefruit seed extract, caprylic acid, undecenoic acid, clove, and other natural antifungals.
Resistance just doesn’t happen.
It happens with pharmaceutical drugs because they are synthetic. They’re only made up of one thing. They’ve got one ultra refined chemical compound with a very narrow band of action.
Once yeast or bad bacteria develops a resistance to this action, the pharmaceutical drug is done.
Remember, these nasty microbes are very adaptive.
If you only hit them with one action they will soon work out how to fool this action.
And you know what happens next. The drug no longer works and the problem comes back. And then you go back to the doctor who puts you on a new drug and the cycle repeats again.
Natural medicines are different. They doesn’t just contain one thing.
They’ve got many different natural chemicals and compounds in there that make it up. They attack yeast, bad bacteria and parasites from many different angles so they get overwhelmed & can’t fight back.
This Means You Can Stop Trying to Rotate or Alternate Back & Forth Between Different Candida Treatments & Just Stick to One Proven Formula Until All Your Symptoms Are Gone...
This Means You Can Stop Trying to Alternate Back & Forth Between Different Treatments & Just Stick to One Proven Formula Until All Your Symptoms Are Gone...
Forget everything you read online about having to constantly switch back and forth between different ingredients or supplements in order to stop Candida from developing a resistance.
You don't need to do that with CanXida Remove.
Even if you take RMV every day for 18 months Candida STILL won't become resistant to it.
If you don't believe this, watch the YouTube video below.
Click the image above to watch video
The 12 Natural Ingredients that Make CanXida Remove Work — Even Against Chronic, Severe & Recurring Cases
- Grapefruit Seed Extract (GSE) (45% standardized) - our favorite natural antifungal, GSE was discovered by Korean scientists to destroy the cell membranes of over 100 different yeast species along with over 800 different pathogenic bacteria WHILE IGNORING beneficial bacteria. A lot of people have trouble taking GSE because of how bitter it is (which is why we put it in a tablet).
- Berberine Concentrate HCL (85% standardized) - Berberine is a natural antibiotic found in herbs such as goldenseal and berberis vulgaris. It has a broad spectrum application in that it not only weakens Candida but is also effective against some of the nastiest bad bacteria such as e coli, staph aureus giardia, entamoeba histolytica, trichomonas vaginalis, leishmania donovani as well as several well-known parasites. And all without harming good bacteria.
- Clove (4 : 1 ratio standardized) - Another herb very effective against yeasts and parasites, clove contains a substance called eugenol which a 2009 study at the University of Porto, Portugal, discovered RUPTURES & DESTROYS yeast cells upon contact. They also found that it almost entirely prevents Candida Albicans from producing hyphae, which are branching filaments that Candida & other fungi use to penetrate the gut wall & spread to other parts of the body. Eugenol was even found to be effective against yeast strains that had become resistant to "azole" medications, one of the most common antifungal drugs used to treat yeast infections.
- Aged Garlic Extract (2% allicin standardized) - Garlic contains allicin, one of the most potent antifungals ever discovered. Studies have found it to be as effective as pharmaceutical drugs such as "azole" & "nystat" drugs for destroying Candida Albicans. You may think 2% sounds small but that's actually a whole lot because when that gets slow released throughout your whole digestive system it's going to have a very strong kill effect on over 800 different kinds of bad bacteria, 20 different kinds of Candida & many, many different kinds of yeasts species such as microsporum, geotrichum, aspergillus and more. Yeast hates garlic, particularly standardized, because it can't develop a resistance to it. (Don't worry if you can't handle garlic or are sensitive to it).
- Caprylic acid - a short chain fatty acid derived from coconut which has been found to stop Candida from replicating. It's perfect for a sustained release formula like this one because the effect isn't too strong but at the same time it's not something yeast can develop a resistance to. Caprylic acid works best in conjunction with undecylenic acid but sadly these are rarely found together in one formula.
- Undecylenic acid - a fatty acid that comes from castor bean. It's a little more potent than caprylic acid but prefers a slightly more acidic environment to work. Our team has tried well over 100 Candida killing products in different combinations and we've consistently found undecenoic acid and caprylic acid to kill off a wider range of Candida species when you combine them vs if you take them alone.
- Betaine HCL - another ingredient that works extremely well with a caprylic & undecylenic acid combination. Many people with Candida have pH issues in their small intestine which would inhibit the effect of undecylenic acid if betaine wasn't present. When slow released, it lowers the pH a little in the environments where these two acids work together. Betaine also ensures undecylenic acid works exactly where it needs to, which is the duodenum and ileum (the two parts of the small bowel most affected by Candida). This is a very strategic combination you won't find in another supplement.
- Black Walnut Hull Extract - contains substances called tannins, one of which is juglone, which according to a 1999 University of Mississippi study is more effective at wiping out worms, parasites and yeasts than commercially available pharmaceutical chemicals such as zinc undecylenate and selenium sulfide and even drugs like metronidazole. Don't worry if you're allergic to nuts, this extract shouldn't cause you any problems.
- Pau d'arco (4 : 1 ratio standardized) - an herb from South America that's often singled out as one of the premier herbal Candida solutions due to research conducted in the 1970's which discovered several dozen different active ingredients in pau d'arco that inhibit Candida and other fungi. Any anti-candida formula that doesn't have authentic pau d'arco should be considered incomplete. (Pau d'arco is often counterfeited due to its high cost so we authenticate ours via lab tests).
- Neem (4 : 1 ratio standardized) - an Indian herb rarely found in Candida formulations. According to a 2011 study published in the Brazilian Journal of Microbiology, neem extract, even at every low doses, has a very strong anti-fungal effect on a wide range of Candida, aspergillus and microsporum yeast species. It is also anti-parasitic.
- Biotin - biotin is a sulphur-containing coenzyme (vitamin) produced by the beneficial bacteria in healthy people that has the ability to halt the growth of Candida and prevent it from maturing into its hyphal & mycelial form (which are VERY HARD to get rid of). Simply put, biotin keeps Candida in check and stops its mycelia from spreading into the bloodstream (where it would then have the opportunity to invade ALL other organs, including the skin, vagina and brain). The interruption of this vicious cycle is crucial if you want a full recovery.
- Oregano Oil (60% Standardized) - one of the most potent natural anti-fungals. According to research conducted in 2001 at Georgetown University Medical Center, oregano oil, when injected into a culture of Candida, inhibits the growth of yeast completely. These same researchers also found yeast infected mice given oregano oil were fully healed within 30 days whereas ones given olive oil were dead within 10. Using oregano against Candida is particularly advantageous because yeast can't develop a resistance against it.
All the Ingredients We Just Listed Have Been Around For A Long Time – We're Simply the First To Source Out Really High Quality Versions of Them & Combine Them All Into One Formula
You'll notice a lot of these say things like 60% standardized and 4:1 ratio.
Standardization means each time you take this supplement, you get a controlled, consistent & therapeutic dose of the active ingredient within each herb.
The strength of the herbs doesn’t vary in potency from bottle to bottle as it does with normal supplements.
It’s a bit like pharmaceuticals are made.
You get the same strong therapeutic dose every time you take it.
Each batch of Remove comes with a Certificate of Analysis from a 3rd party lab proving it's been tested to deliver a guaranteed dose of antifungal compounds. The lab we use is Eurofins Scientific USA — one of the world leaders in pharmaceutical & supplement product testing, with over 950 labs worldwide.
If you email us, we'll even send you a PDF of the certificate.
If you want additional proof, watch the video below where you can see real patient stool test lab results before & after using CanXida Remove. It's all there.
Click the image above to watch video
Standardization is Basically High-Tech Herbal Medicine — It Takes the Randomness Out Using Natural Treatments and 100% Guarantees Yeast Gets Pummeled With the EXACT Doses of Active Ingredients From Herbs Like Garlic, Oregano & Clove that Are Proven to Work
"60% standardized" means this raw material has been concentrated & lab tested to be made up 60% of the active antifungal compound found in this herb.
The oregano oil in Canxida Remove (for example) is made up of 60% carvacrol and 40% other natural oils extracted from raw oregano leaf. Carvacrol is the natural compound responsible for all incredible health benefits & antifungal effects oregano is known for.
A "4:1 ratio" means the key active ingredient has been concentrated until it's 4x higher than is naturally found in the raw herb — meaning you get 4 TIMES more antifungal action.
This is different from non-standardized supplements which simply use untested powders which MAY OR MAY NOT have much of the active ingredient responsible for the antifungal action that herb is known for.
It also guarantees each herb is authentic and you get NONE of that fake ingredient nonsense.
Which means better digestion, less embarrassing bathroom runs and you going back to eating & living like a normal person again faster.
As well as finally being able to go out and enjoy meals again at restaurants & family gatherings...
But Wait, There's More — CanXida Remove Is Also Sustained Release
Sustained release means when you swallow this tablet, your digestive system doesn’t get access to everything immediately. But over a period of 6 hours it slowly breaks down in the gut.
That way it targets all parts of your GI tract. It cleanses all the yeast and bad bacteria right from your mouth and keeps working all the way through the colon and “back passage.”
Having CanXida Remove sustained release also lets us pack each tablet with higher doses of standardized ingredients — without them causing side-effects, irritation or die-off reactions.
Think of it as taking 10 cloves of garlic at once, but having all that antifungal activity get spread throughout the day vs hitting you all at once.
You End Up With a MUCH Stronger Cleansing Effect — Without the Discomfort, Irritation, Side-Effects or "Die-Off" Reactions
Now, likely the supplements you were taking before weren't standardized or sustained release.
They weren’t put together by someone with decades of experience treating your specific health problem.
They were likely put together by a company that’s got 100 other supplements & they paid lip service to making a gut cleansing formula. Or they just picked a few herbs that looked good and then bought the cheapest version of them they could find — without doing ANY testing or authentication.
Forget all those "new breakthrough" methods & weird products on the market right now.
Most of them are ABSOLUTE NONSENSE, a "flash in the pan" created by people who've come out of nowhere just to make a quick buck and disappear.
None of them have the clinical experience CanXida has behind it.
Summary Info For CanXida Remove (RMV):
Remove is the ultimate first step to getting your yeast levels back to normal & has been used by tens of thousands of patients worldwide (often when every other formula failed them).
CanXida Remove Is:
Designed to be effective against all 20 most com80mon Candida species (Candida albicans, Candida tropicalis, Candida krusei, etc.) plus over 150 other yeasts such as Aspergillus, Trichosporon, and Rhodotorula. As well as over 800 different species of bad bacteria including some of the nastiest such as e. coli, staph aureus, giardia, entamoeba histolytica, trichomonas vaginalis & more, along with a broad spectrum of parasite invaders.
- Sustained release (targets all parts of the GI tract including mouth, stomach, intestines & colon).
- Effective against yeast, bad bacteria & parasites.
- Non-toxic and can be taken long term.
- Gluten-free & vegan friendly.
- Does not harm beneficial bacteria.
- Ruptures & destroys bad microbes & yeast cells upon contact.
- Prevents pathogenic (bad) bacteria from reproducing.
- Supports a healthy GI tract and gut-related immune function.
- Natural herbal solution (gentle & safe even for seniors and children).
- Does not cause bad "die-off" reactions or side effects.
- Formulated so yeast, bad bacteria and parasites cannot become resistant.
CanXida Remove Sells For $59.99 Per Bottle on CanXida.com — But As a Special Thank You For Taking Our Quiz & Reading This Far...
We'd like to offer you a special one-time discount offer for first time buyers ONLY.
Instead of $59.99 for one bottle or $119.98 for two, we'd like to offer you 50% OFF — 1 bottle for $29.99 or 2 bottles for $59.98 — PLUS FREE USA SHIPPING with either option.
Here are the 2 options:
Free USA Shipping On All Orders
We'd also like to give you a free gift — ALL 9 of our PDF eBooks & special reports for FREE.
You'll get CanXida Remove, plus...
What's Included in this Free Candida PDF Bundle:
- Candida Crusher: A Permanent Yeast Infection Solution Based on 30 Years of Experience Helping Thousands of Patients (718 pg)
- The Complete Candida Elimination Diet for Beginners — An Easy to Follow 3-Step Candida Diet & Cleanse Based on 30 Years of Experience (64 pages) (64 pg)
- 21-Days To Fix Your Gut Health: A Step-By-Step Guide to Healing Your Gut of Candida, Leaky Gut, IBS & Almost Any Other Digestive Problem (67 pg)
- Candida Friendly Recipes: 40+ Delicious Recipes to Alleviate Symptoms & Restore Gut Health (94 pg)
- The Candida Symptoms Tracker (6 pg)
- Candida Crusher Recovery Workbook: An 8 Week Diary & Planner to Help You Build a Diet & Action Plan That Works (174 pg)
- Candida Crusher Diet One Page Printable Checklist (1 pg)
- Candida Cleanse Progress Tracker (1 pg)
- Anti-Candida Diet Monthly Meal Planner (8 pg)

You may be interested to know that Candida Crusher is currently ranked in the top 2 bestselling books on Amazon in the Candida category.
We won't go too in-depth into what's inside each of these manuals but we will go over Candida Crusher as it's the largest.
This book is currently sold for $22.30 on Amazon.
This is the ONLY PAGE on the internet you can get in PDF it for FREE.
You can't get it if you close this page & you can't get it if decide you want to purchase CanXida later from canxida.com.
Trust us, if you think the YouTube videos are packed with great info, wait until you see Candida Crusher.
In Fact We've Been Told By Many Practitioners That It's One of the BEST & Most Comprehensive Books On Candida They've Ever Seen
THIS BOOK IS MASSIVE and UNLIKE anything you've ever encountered before in all your Candida research.
The table of contents alone is 22 pages long.
It's got over 200 pages on diet, 50 pages on the link between Candida and stress, 70 pages on lifestyle, 35 pages on detoxifying, many pages on diagnoses & laboratory tests, tons of information on the correct herbal treatments, the correct washes, cleanses, & much more.
Here's what the forward of the book looks like, written by Dr. James L. Wilson, ND., D.C., Ph.D. and author of the bestselling book Adrenal Fatigue, the 21st Century Syndrome.
Foreword To Candida Crusher By Dr. James L. Wilson
“Candida overgrowth is not something to take lightly. That is why there is such a need for a book like this. This book takes Candida treatment to the level it needs to be taken. It is a breakthrough book for this generation like Dr. William Crooks books were to the generation of the 1980s.
This book is a quantum leap forward and allows the reader to successfully treat what can become a persistent health problem that continually pulls down your overall health. This is a book providing a comprehensive protocol to truly help regain your health and be free of the Candida scourge. This is a book you can rely on and use as a guide to get yourself back to health.
If you are the patient, you can give a copy to a trusted doctor and say, “this is how I want to be treated”. If you are the health care provider, you can use this as a guide to help you establish a written protocol to successfully treat this commonly occurring health problem.
If you have to go it alone and treat yourself, you can use Candida Crusher as a reliable guide to get yourself out of the woods and on your way to a “Candida-free” life. It’s not because the book contains a lot of information – although it does, that makes it so useful. It is because it is written from the perspective of a physician with a lot of years of experience and from a place of wisdom that can only be obtained through seeing thousands of patients, pouring over books after hours and a commitment to helping people recover their health, not just feel better.
In my many conversations with this naturopath, I have come to know him as the real deal. A lot of doctors write books on health and disease. Few are written with the abundance of practical information combined with scientific understanding like this book. I believe this book is destined to become a classic and invite you to read and follow its instruction because in my opinion, it is the best, most practical book addressing the Candida problem ever published.
This is a book that has been needed for a long time, but needed someone with vast knowledge & experience to write a book like this. Use this book as your guide and then contact him to thank him and provide your feedback. That is the true reward to an author who writes at this level."
Dr. Wilson is acknowledged as an expert on alternative medicine, especially in the area of stress and adrenal function, and is a respected and sought after speaker in the medical and public communities in the United States and abroad.
Dr. Wilson regularly speaks at some of the most prestigious medical conferences including:
• the American Academy of Anti-Aging Medicine (AAM);
• the American Academy for Advancement in Medicine (ACAM),
• Fellowship in Anti-Aging and Environmental Medicine (FAAFM),
• the American Academy of Environmental Medicine (AAEM).
In Addition to These 9 FREE eBooks, You'll Also Get a Physical Copy of Our 28-page CanXida User Guide
This small 8 by 5 inch booklet is FREE and included with all new orders.
You'll also get a PDF version of it in case you lose it or prefer to read on a screen.
Inside you'll find a detailed guide on how to use each of our formulas. Plus...
- Dosages for different gut problems.
- How to take CanXida if your symptoms are severe.
- Why you must ALWAYS take CanXida with meals (& never alone).
- The #1 best foods to eat with CanXida for best results.
- What dosage to start with & when to increase or decrease it.
- How long does it take each CanXida formula to start working.
- How long to use CanXida for.
- Who each of our 4 CanXida formulas are for.
- How to cut your recovery time in half by taking an extra dose or Remove at a certain time of day.
- How long to stay on CanXida before taking a break.
- CanXida frequently asked questions.
- And much, much more...
We tried our best to answer any questions you may have regarding how to use CanXida to best tackle your specific health problem, but if you want to contact us for additional help...
Please reach out to us at support@canxida.com or call us toll free at 1-(888)-508-3171.
All major credit cards are accepted.
You can also order over the phone by calling us toll-free at 1-(888)-508-3171, Mon–Fri 9am – 4pm Eastern Time. The wait time is usually 3 minutes. Just mention the 50% discount and you'll get it.
When you're ready to order, click one of the Add to Cart buttons below:


Free USA Shipping On All Orders
Trust US, We KNOW What It's Like to Suffer From Candida
Many of our support staff had Candida at some point in their lives. We know how you're feeling.
We know the feeling of despair and frustration associated with bouncing from doctor to doctor and having each one tell you nothing is wrong & prescribe you the same medications that do nothing but make you feel awful & send you back to square one.
We know about the chronic constipation, the discomfort, the overwhelming fatigue, the misery, the depression & everything else.
We know about the constant bloating and horrible gas & having to wear loose or baggy clothing because your stomach swells so full you feel like you're pregnant & how all this is affecting your job & your social life.
We know about how often you run to the bathroom. The self-doubt you feel when doctors tell you it’s “all in your head.” The embarrassment of telling someone you have “problems" down there. The feeling of being “unclean” after you’ve just showered. The itchiness, irritability, depression, sugar cravings & weight issues.
We also know you've tried many other solutions already.
They didn't work so well did they? Maybe you were able to get rid of your symptoms for a few weeks or months only to have them all creep back up on you.
We've been at this for many years now & let us tell you now, the biggest mistake you can make with a Candida is to ignore it thinking it’ll go away. It won’t go away. In fact it’s not uncommon for new patients to contact us saying they’ve been suffering with these symptoms for years!
That’s why we urge you to take this first step towards recovery and give CanXida Remove a try.
Even if you only get one bottle, we promise it'll be the best $30 you've ever invested into your health.
Customers tell us all the time that they had no faith whatsoever in natural supplements before trying Remove. And if that’s how you feel that’s OK, because we know you’ll be amazed at how much better you feel within just your first week of being on CanXida.
Don't Take Our Word For It — Just Look At All These Success Stories
Click the image above to watch video
TWO WORDS: IT WORKS! “I would sum up my CanXida experience in two words: It Works. I find that if I stick with it, the results are much better than with any other treatment, and I have tried literally dozens.”
- S. Queensland, Australia
NOTHING ELSE HAS HELPED! “My itchiness abated, my skin texture was smooth & clear. I don't have as much sinus issues & I feel like it is helping with bloating. I've had Candida overgrowth for 35 years & NOTHING else has helped.”
- Kellie. Michigan
10 YEARS OF RUNNING TO THE TOILET GONE! “Food intolerance for 10 years gone. 15 years of loose stools gone. 10 years of running to the toilet 6 times a day gone. Lots of gas at both ends gone.”
- M. Melbourne, Australia
BY FAR THE BEST OUT THERE! “Huge results. I had severe candida. I have been taking your products and following your protocol for over a year and I am seeing steady improvement. It takes time and diligence but your videos and canxida products are by far the best out there. My constipation, gas and bloating is improving. Rashes are leaving. Etc. Canxida is the real deal. Full of integrity and good quality products. Thank you!!”
- Jen. Kansas City, Missouri
IT’S CLEAR THEY TRULY WANTS PEOPLE TO GET BETTER! “Two months ago I was absolutely miserable and in constant pain. Each day I was reacting to more foods and things eventually became so terrible that no matter what I put in my mouth, my belly blew up to the point that I couldn't even do my pants up anymore. My chiropractor recommended Canxida and I had a thorough look into the brand. The selling point for me was how much information they were giving to the consumers. I could easily find the answers to all of my questions. It's very clear that they truly actually want people to get better and aren't in this for the money. Which is unfortunately a rare find these days.”
- Stella. Australia
HELPED ME GET WELL AGAIN! “I have improved immensely. I was very sick with Candida for quite a few years before I finally realized what was causing the physical problems. Using the CanXida products and following your advice has helped me to get well again. I still use the Remove and Restore and probably always will.”
- Linda. Ontario, Canada
I'VE HAD THE BEST RESULTS! “I went to a few doctors and they gave me so many medicines, I kept trying over the counter meds, nothing was working. I found canxida & I've had the best results.”
- Megan. Olympia, Washington
Click the image above to watch video
GOT RID OF BLASTOCYSTIS! "Canxida Remove was the key to getting rid of a parasite in my body, Blasto Hominis. Canxida Restore was the necessary, quality probiotic follow-up. I watched 5 short videos on the youtube channel and was convinced that I would benefit from these products, Canxida Remove and Canxida Restore. That proved to be true!”
- Liam. Colorado
HEALED ACNE ON MY BACK! “So happy that it helped heal my acne (on my back)! Huge confidence booster, for sure. And so happy that it improved my digestion. :)”
- B. Texas
NO OTHER PRODUCT WORKED! “I was very thankful to get relief from symptoms of Blastocystis Hominis when no other non-prescription product I had tried beforehand had worked, including some of the most respected practitioner-only brands on the market.”
- Jena. Australia
GIVEN ME MY LIFE BACK! “Taking Canxida, along with a complete diet overhaul, has given me my life back. My husband told me, “You are like a whole new person!”
- C. Indiana
MORE ENERGY! “My health has improved since I started to take the 3 CanXida back in November last year. Not only it has improved my gut issues but my periods are more regular and not that painful as it used to be. The best of all is that I feel a lot more of energy instead of the extreme tiredness that I was experiencing. These products really work and I will keep taking them.”
- Angela. Texas
30 YEARS OF ITCHY SKIN GONE! “I have been suffering from increasingly itchy skin for over 30 years which began with the pregnancy of my first child. Doctors, midwives, holistic practitioners, everyone I consulted with on the problem brushed it off and suggested topical remedies. It had become unbearable, and by chance or miracle, I came across your quiz on social media. After reading some of the testimonials, watching some of your excellent videos, and getting the results from the quiz, I was certain I had found the problem. It made perfect sense. I immediately purchased and began with the CanXida Remove + Restore and within a few weeks I noticed a marked difference, and now two months into the protocol, I am nearly itch-free. I also noticed that the inflammation in my joints has diminished quite a bit, and I have far less bloating in my abdomen. I have since committed to continuing with the Remove + Restore + Rebuild and expect to follow the regimen as long as it takes. I know I will ultimately feel healthier and overall, much more happy in my body. Thank you for all of your informative videos and articles.”
- Teri. San Marcos, California
TOENAIL INFECTION CLEARED! “I noticed the small things first... (I only bought one jar to see if it agreed with me I’m waiting for my next shipment to arrive) but with only one jar my brain fog cleared and the infection on my toenails cleared I’m so impressed...I still have my recurring thrush but I didn’t change my diet! When my lot comes I intend to go all out to get rid of this once and for all!”
- K. United Kingdom
Click the image above to watch video
OVER 10 YEARS OF RECURRING YEAST INFECTIONS GONE! “Absolutely changed my life. I got rid of my yeast infection for good. It had been recurring for over a decade. I finally have relief. My entire body is healthier. My oral health, gut health, foot health have all cleared. I also got rid of dry skin. I will forever be grateful. I also have eliminated alcohol from my diet and have changed my lifestyle to include more vegetables and exercise. It's a complete change that's needed. Your advice and products have brought me my life back.”
- Courtney. New Jersey
SAVED MY LIFE! “I will never put any other supplements in my mouth on the market other than Canxida. Also I won’t ever recommend any other program than the Candida Crush program. It actually saved my life. Thank you. Me and my members in my FB group Candida Cleanse Sweden can’t say thank you enough for all you’ve done for us <3.”
- Natalie. Sweden
HEALTHIER SKIN AND NAILS! “After 3 weeks on the CanXida supplements I am already starting to feel a difference. I don't have as much brain fog, I'm sleeping better at night, my intestinal spasms are less, I have more energy, my hair and skin feel healthier, and I'm having daily bowel movements, whereas before I was only having them every other day. After dealing with these symptoms for decades, my results so far are encouraging, even after a short period of time. I've told my sister about my experience and she is looking into these protocols as well. Thanks!”
- Lisa. Utah
BEST I’VE BEEN SINCE I GOT ILL! “I've suffered from parasites for three years. I now have anxiety as well. I'm the best I've been since I got ill. While using these products I went from having zero energy and drive to being able to get through the day. My Naturopath says it's the best formula he has ever seen and that nothing he could prescribe me could come close to Canxida products.”
- Elly. Australia
I HAVE BETTER SLEEP! “It helped me and its been helping me, I started with 2X a day then lower to once per day. I used to feel so bloated and not so normal after I eat. But now I don't feel like that anymore. I have better sleep most of the time now. The supplements really work.”
- M. Philippines
LESS ITCHY WITHIN DAYS! “I have only been taking it for a few days but I am already feeling a little less itchy. Great product!”
- Alexandra. Seattle
FINALLY HAVE A LIFE AGAIN! "Slowly but surely the countless amount of symptoms I was experiencing on a daily basis gradually subsided. I still have a few left but far less than before. I can manage my day to day chores easier, I have a life, whereas seven months ago I could barely do anything. I aim to further my treatment till the overgrowth has subsided. Thank you for these wonderful products.”
- Christian. France
LITERALLY SAVED ME! “Don't mean to be dramatic but your youtube channel and articles literally saved me. Horrific constipation and chronic yeast infections ruled me for so long and I finally don't have to worry about it 24/7 now. Symptoms are improving and I can finally focus on my studying. Not to mention there is literally a video on every topic one can think off on your channel.”
- Karishma. Trinidad
AMAZING LAB RESULTS! “I'd been watching the youtube videos with interest for a few months and then I saw the one with the before and after lab tests on a guy with inflammation and parasites that went away so I bought the $399 deal on the spot.”
- Rebecca. California
MONTHLY YEAST INFECTIONS GONE! I was getting a vaginal yeast infection every month at the time just before my period started. They're gone now!”
- Lindsay. Missouri
LOST LOTS OF WEIGHT! “After a couple of very sick months I felt fantastic, plus lost lots of weight!”
- Mathew. Greece
IT’S HEALING MY ECZEMA! “My eczema has begun to calm down, my skin looks and feels healthy and I feel more energetic!! I’m 52 and feel better than I have in years!”
- Paula. Pennsylvania
MY GUT FINALLY FEELS NORMAL! “It's the only product that has helped me in over ten years suffering from blastocystis hominis. When I take the Remove and the Restore, my gut finally feels "normal" again.”
- Janae. Oregon
Click the image above to watch video
MIGRAINES GONE!
“For 4 years my family doctor has prescribed me Fluconazole and Metronidazole to treat my infections. I went along with antibiotics, I trusted my doctor when she said "unfortunately some people are just prone to vaginal infections and we can only "cure" it with antibiotics". I had regular migraines and brain fog followed by joint pain, ringing ears, bloated stomach. I just didn’t feel right knowing my doctor was just treating the symptoms and not the root cause. I purchased Canxida Remove in April 2020 as I was just getting fed up of taking antibiotics for my recurrent infections. Not long after a week of taking the supplement I could feel a massive improvement to my symptoms. It really has been a relief to finally find a natural product that is good in quality and is helping me to get my health back on track. Since taking Canxida I’ve not had a migraine (usually at least one headache a week), my joint pain has eased and my vaginal infections have decreased in the number or attacks. I plan to continue taking Canxida supplements as I am confident that they will fix my illnesses once and for all. THANK YOU for all the work and research you have and are doing to help candida sufferers like myself have a voice and not just another patient brushed aside and not believed in.”
- Erica. United Kingdom
MY SUGAR CRAVINGS DISAPPEARED! “Within a month, my sugar cravings completely disappeared - I had no idea I could feel that way! I no longer have brain fog, I sleep better, and my acne has greatly improved. Prior to taking Canxida I was trying to address my issues through my diet, and it was really difficult.”
- Christina. Hawaii
FEEL NORMAL AGAIN AFTER 15 YEARS! “It changed my life. Over 15 years I couldn’t find the answer to my problems. I feel so happy with the improvement that I cherish every moment of my life. Thank you! I feel normal again after so much time.”
- Liamm. Bulgaria
REALLY GRATEFUL FOR PRODUCTS THAT WORK! "I've been on Canxida for a little over a month now and have noticed a marked difference in my stomach pain and upset. I am really grateful for products that work! When I joined your emailing list I really appreciated the daily e-mails. They made me feel not so alone and like I really can kick this sickness.”
- Krissy. Vancouver, Canada
I FELT SO MUCH BETTER! “I felt so much better! My daughter also took it and was thrilled that she finally got her yeast under control for the first time in her life. It improved her general feeling of wellness for the first time, after trying so many things. I've been and will continue to take the multivitamin as I have a malabsorption problem and desperately need a good one, and I know the quality of this will continue to fill my nutritional needs.”
- Beverly. New York
IBS & SIBO SYMPTOMS GONE!
“I suffered from major bloating and IBS symptoms, as well as sometimes having to immediately run to the bathroom because of bowel issues. Sometimes I had bathroom emergencies when I was not at home and would have to literally run to find a rest room. The bloating was so bad that it made me look pregnant. I had heard about SIBO and thought that may be my issue but did not know how to go about healing my gut. The information out there was confusing and I needed an actual plan to follow. I am so grateful for finding your website and youtube videos. I had results very quickly because I followed the plan exactly. Any extra weight that I had literally fell off me, I lost about 20 pounds and I was actually a little underweight! My stomach was flat again for the first time since having children. I had no more bathroom emergencies, peace of mind when out shopping, etc. IBS symptoms - gone.
- Kristen. Ontario
Click the image above to watch video
IT’S TAKING AWAY MY NAUSEA!
“The Canxida has helped in taking away some of my nausea, which had gotten severe for a long time. I’ve tried other products that actually made my symptoms worse. I know that Canxida will treat whatever is going on in my gut, which is fantastic. I can’t afford to have a bunch of different testing done, but I was also at my wits end with dealing with gut problems, and all the symptoms that comes with it in other areas of the body, so I’m happy this product will take care of the problem whether it’s parasites, leaky gut, or Candida. Your videos have offered so much insight that I try to soak up whenever I get the chance. They give me that assurance that I’m not stuck feeling terrible and that I will be healthy again. I can’t thank you enough. Bless you for these!!!”
- Hope. Oklahoma
I CAN EAT WHATEVER I LIKE!
“CanXida Remove is a game changer. My symptoms disappeared and have never returned. I can eat whatever I like without trouble. I'm sold. Even my GI doctors thinks it's a great product.”
- K. California
THE MOST ENERGY I HAD IN 3 YEARS! “Canxida is what has helped me the most in recovering from my yeast condition. I experienced the most energy, true joy and mental clarity than I had within the past 3 years. It gradually felt easier to get out of bed, I wasn’t as tired as before. I was able to concentrate better when reading or listening. I felt more positive and hopeful in life. I enjoyed my social interactions more.”
- Linda. Florida
ALMOST ALL MY SYMPTOMS ARE GONE! “Within 1 month I was going to the bathroom regularly. My constipation and acid reflux eased up SUBSTANTIALLY. This gave me a big boost of motivation to continue. I began doing the whole Canxida cleanse and for the past year and a half till now I have seen consistent results. At this point almost all my symptoms are gone. My muscle pain is so much less. My brain fog decreased. My anxiety and depression decreased. I am taking responsibility of my life and health and replacing bad habits with good habits. Canxida is not just taking some supplements.”
- Levi. Chicago
I ALMOST CAN’T BELIEVE IT! “I had recurring yeast infections for 12 years. I tried all kinds of probiotics, garlic supplements, yogurt, kefir, boric acid suppositories, tea tree oil, caprylic acid, oil of oregano, fluconazole taken preventatively 7/month, zinc/infused underwear, abstained from sex, couldn’t ride my bike, feared the heat of summer. Discovered Canxida Remove in summer 2021. Been taking it since. My yeast infections have stopped. I almost can’t believe it. Your product changed my life. Thank you!
- Mona. Canada
IT’S WORTH EVERY PENNY!
Been on and off various supplements that don’t work. I’ve tried the remove before and it's the only thing that works. It's worth every penny. It was great when I was on it. It's literally the only thing that cuts my sugar cravings.”
- Shanna. Massachusetts
Click the image above to watch video
I WENT FROM HOUSE-BOUND WITH BLOODY STOOLS!
Excellent! Near complete remission of Ulcerative Colitis and positive impact on skin and nail problems. Much improved digestion. I went from house-bound with bloody stools and urgency and being severely underweight to near 80% normalcy. I recommend these products to anyone I know/meet who has issues, and to my chiropractor to pass on to other clients with problems. Thank you!”
- David. Australia
MY STOMACH FEELS NORMAL! “I have suffered with yeast problems since I started taking antibiotics for acne at age 13. Over the years I have suffered with chronic fatigue, depression, constant stomach problems, and autoimmune issues, and chronic UTI’s. I have allergies and a histamine intolerance. I have had a great response to the CanXida remove and restore. No side effects what so ever! I am even eating a few things that would have negatively affected me in the past. My stomach feels normal, my allergies are better, no UTI’s, my scalp is not red. After the second month my vaginal yeast is better, too. I never miss a dose, and I am so grateful to be feeling more normal and enjoying life.”
- Vaughn. Georgia
CHRONIC UTI GONE! “Chronic UTI gone! Bloating, smelly farts, hives, sensitive teeth, mouth/cold sores, herpes, acid reflux, anal/crotch itch, itchy skin all also gone! Hashimoto's Thyroiditis under control! Depression, foggy brain, lethargy, sleepiness greatly reduced. You are the best. Thank you!
- Leilan. Hawaii
MY CONSTANT DIARRHEA STOPPED! “My constant diarrhea has stopped. I was at the point where it was preventing me from leaving the house. I had been diagnosed with the blastocystis parasite 7 years ago and after taking antibiotics several times it was only getting worse.”
- Susan. Vancouver
MY ECZEMA COMPLETELY HEALED! “My very mild eczema became horrible—itchy, spreading, unsightly—in early 2020. Dermatologists, doctors and even the one naturopath I saw were of no help whatsoever. In fact, one dermatologist told me that my condition had nothing to do with food, and that it would be a lifelong affliction. I was beside myself with grief. With nothing to lose, I turned to the internet to find answers and was extremely fortunate to find your outstanding videos. After binge watching them, trying to recreate CanXida Remove product on my own with all the various ingredients, and cleaning up my diet—and still not achieving success—I took the plunge and ordered a bottle of CanXida Remove. The morning after I had taken a few of the Remove capsules, I KNEW it was going to work. In that short length of time, my angry, itchy skin looked and felt better. My feelings of hope were restored. After taking Remove—and then, a few months later, Restore—for the better part of a year, eating tons of keifer, plain yogurt and sauerkraut, removing most (even good) carbohydrates from my diet, and eating a lot of non-starchy vegetables, greens, good proteins and good oils, I am now COMPLETELY healed. I am grateful beyond measure. Thank you!!!!! You saved my life.”
- MaryAnn. Canada
Click the image above to watch video
You May Think $30 or $60 for Supplements Is Expensive But...
CanXida is cost effective because you can stop buying all the other supplements you're taking.
Think about it. How much have you already spent on supplements to get your health back? $100? $500? $1000 or more?
Some people write to us, “jeez, why are your formulas so expensive?”
We challenge you to go out & make a product like this & sell it for a lower cost using the same raw ingredients. You’ll end up with a cheaper product and you’ll get cheap results.
And then you’ll see people talk about it on the internet and tell everyone how bad your product is.
We don’t want cheap results.
We sourced the best possible raw materials from the top manufacturers in the world for our CanXida formulas.
We Know the Suppliers Where Each Raw Material Comes From, We Know How It's Grown, We Have Lab Tests From Each Batch To Make Sure They Have the Right Amount of Active Ingredients
Each raw material goes through a stringent processes involving lab work to make sure the correct herb was sent, that it contains no contaminants or bad microbes, that there are no heavy metals, PCBs, dioxins, GMO's and more.
We also know all the people involved in the production of these supplements are in Canada and the USA & NOWHERE else.
Once all the herbal ingredients are verified, they're sent to a top of the line GMP certified facility in New York to get compressed into tablet form.
After that, the bottles are sent to Bose, Idaho, which is where we ship from.
Most people can't be bothered by these things or don't care — they just go to Amazon or the supermarket & look for a cheap $10 product.
And if that's your motto, maybe CanXida isn't for you.
CanXida is not cheap but great health is not cheap either.
And believe us, the price is long forgotten when your health returns and your quality of life improves.
We can’t begin to count how many people we’ve seen get their health back using this protocol after all the drugs & doctors visits got them NOWHERE.
Stop Putting Up With the Pain, Embarrassment, Self-doubt, and Unsupportive Doctors
Think about it.
30 days from now you can be where you are now, still feeling like a prisoner in your own body and having to suffer daily with all the nasty and embarrassing gut issues that have been plaguing you for so long...
With likely nobody who understands what you're going through.
Or you could be several weeks into the plan we outlined for you above and have already eliminated half or more of your symptoms.
We have absolutely ZERO DOUBT this protocol is going to change your life because of the response we've gotten from people.
Think about it.
30 days from now you can be where you are now, still feeling like a prisoner in your own body and having to suffer daily with all the nasty and embarrassing gut issues that have been plaguing you for so long...
With likely nobody who understands what you're going through.
Or you could be several weeks into the plan we outlined for you above and have already eliminated half or more of your symptoms.
We have absolutely ZERO DOUBT this protocol is going to change your life because of the response we've gotten from people.
We Know You're Skeptical – Do All the Research You Like – You Won't Find A Better Solution To Your Candida Problems
If you're still skeptical whether or not CanXida will work for you, check out the CanXida YouTube channel.
Watch the videos on this page (such as the one below).
Click the image above to watch video
Remember, CanXida isn't just about taking a supplement.
There's 2,993 FREE candida and gut health videos on our channel and more are added each month.
We’ve got videos on what foods to eat & avoid for different issues, how to quickly tackle symptoms like bloating
& acid reflux, how to tell if a probiotic is high quality, & so much more.
If You Can Think Of It, We Probably Made a Video About It
And if we haven't, you can always email us and ask us to a new video on a certain topic. We do it all the time.
We've even got a Candida Recipes channel.
There's a CanXida Customer Stories Youtube video playlist with 22 more videos like the 7 you saw above.
Spend a few minutes browsing around. Do a search for any gut health related topic you can think of. Chances are we've made a video about it.
If you prefer to read, check our the articles on yeastinfection.org or blog.canxida.com
We've got videos showing stool test lab results before and after a person took CanXida, dosage information, food questions, how to tackle specific symptoms that just won't go away...
Click the image above to watch video
Verify Whatever You Like – Then Click Add to Cart & You'll Be Taken to a Page Where You'll Have Plenty Of Time to Make Your Final Decision
Just make sure you don't close this page because this is the only time you're going to see it.
This is the ONLY page on the internet where you can get CanXida at 50% off & receive an instant download of our 718-page Candida Crusher ebook.
Along with free copies of The Complete Candida Elimination Diet for Beginner, Candida Friendly Recipes, 21-Days to Fix Your Gut Health, Candida Symptoms Tracker and several more...
Also note that supply is limited.
CanXida shortages are unfortunately very common and you can see that if you check the comments section of our YouTube videos. We get Remove in limited runs and since making this page, we're probably going to need to increase production yet again to meet the demand.
When you're ready to start your recovery process, simply grab your credit card leave it by your computer or phone. It's time to decide if you want to start with 1 or 2 bottles of CanXida Remove.
If your symptoms are mild or you just want to "test drive" our system, grab a single bottle for $29.99.
If you're chronically unwell or your symptoms are severe you want to get 2 bottles so you’ve an extra one sitting there ready to go.
CanXida saves you money because you can stop spending hundreds (if not thousands) on other treatments.
This Is the Candida Solution You've Been Scouring the Internet For
We promise you're not going to find anything more effective no matter where you look.
All you have left to do is click the Add to Cart button bellow for the pack you want & you'll be taken to a page where you'll have plenty of time to make your final decision.
If you still have questions about CanXida, call us toll-free at 1-(888)-508-3171 or email support@canxida.com (or simply send us a message on YouTube).
You can also order over the phone by calling 1-(888)-508-3171, Mon–Fri 9am – 4pm Eastern Time. The wait time is usually 3 minutes. Just mention the 50% discount and you'll get it.
We look forward to speaking with you again.
-Deborah Barnes, CanXida Customer Care Team
P.S. Remember this is the ONLY page on the internet where you can get CanXida Remove at 50% off plus FREE PDF copies of all 9 of our Candida ebooks AND a FREE print copy of the CanXida User Guide 28-page booklet which contains a detailed dosage guide depending on if your symptoms are mild, moderate, or severe.
All major credit cards are accepted & shipping is free if you're in the USA. We promise you won't find anything better no matter where you look.
Click one of the 2 options below and we'll see you on the other side.
Click One of the Options Below... Right Now
Free USA Shipping On All Orders
Remember, each order comes with ALL 9 of our PDF eBooks & special reports for FREE.
You'll get CanXida Remove, plus...
Copyright © 2011-2025 by CanXida. Oppenheimer Tower, 10880 Wilshire Blvd., Suite 1101, Los Angeles, California, 90024, USA
Phone: 1 (888) 508-3171